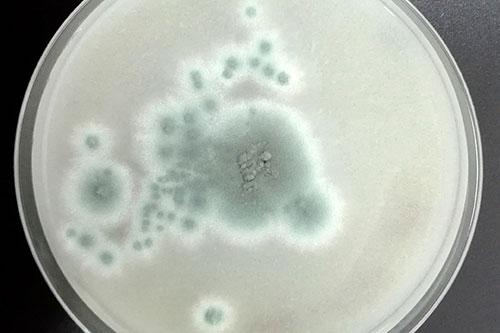
Estudios revelan que hongos peligrosos podrían expandirse por el mundo. Créditos: U. de Chile.

Científicos alertan que un hongo real podría expandirse como en The Last of Us
Un hongo similar al de The Last of Us preocupa a científicos por su expansión global y efectos graves. En Chile ya se han detectado casos.
Un reciente estudio ha alertado a todo el mundo, ya que un tipo de hongo letal podría propagarse más rápido de lo esperado debido al cambio climático. Aunque suena a una trama de ciencia ficción como la serieThe Last of Us, la advertencia es completamente real y proviene de expertos de la Universidad de Manchester, respaldados por la fundación Wellcome Trust.
El protagonista de esta preocupación científica pertenece al género Aspergillus, un grupo de hongos que habita naturalmente en el aire, el suelo y hasta en nuestro propio cuerpo. Aunque muchas de sus especies son inofensivas, otras pueden causar graves infecciones respiratorias e incluso afectar el cerebro, especialmente en personas con sistemas inmunológicos debilitados.
Como en The Last of Us: Estudio advierte que hongos peligrosos podrían propagarse a nivel mundial
Según los investigadores, el cambio climático está creando condiciones ideales para que estos hongos se expandan. Incluso en un escenario moderado, con un aumento de solo 2 °C, especies como Aspergillus fumigatus, flavus y niger podrían extenderse en regiones como Escandinavia y el Reino Unido, afectando a millones de personas.
El doctor Norman van Rhijn, autor principal del estudio, advierte que los hongos son “extremadamente difíciles de tratar” debido a la escasa cantidad de medicamentos antifúngicos eficaces. Además, más del 90% de las especies de hongos aún no han sido estudiadas, lo que aumenta el riesgo de que nuevas amenazas surjan sin que existan tratamientos disponibles.
¿Está el hongo en Chile?
En abril de este año, el Ministerio de Salud cerró de manera preventiva cinco pabellones del Hospital El Pino, en San Bernardo, tras detectar dos casos de aspergilosis pulmonar. Aunque los casos fueron controlados, el episodio demostró que esta amenaza ya es parte de nuestra realidad.
¿Qué es la aspergilosis invasiva?
Es la forma más grave de infección por Aspergillus. Comienza en los pulmones, pero puede diseminarse a otros órganos, incluido el cerebro. Según estimaciones, esta enfermedad provoca cerca de 1,8 millones de muertes al año en todo el mundo.